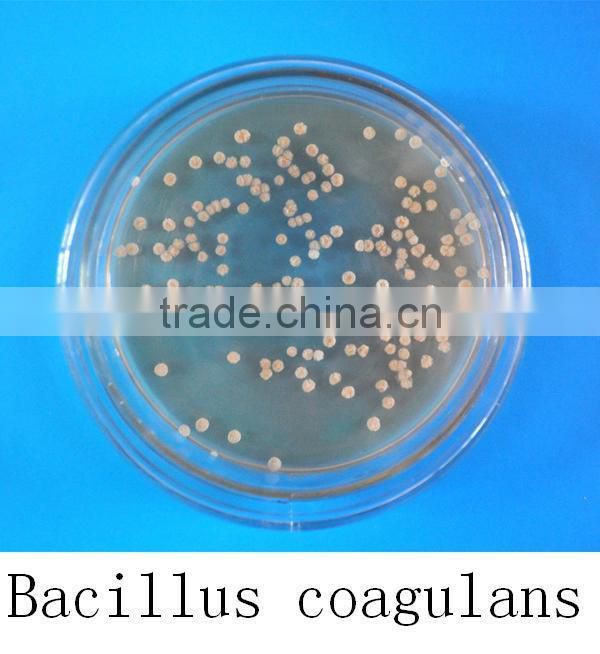
(Lactic acid-forming bacillus bacteria) Bacillus coagulans

(Lactic acid-forming bacillus bacteria) Bacillus coagulans
Product description
Bacillus coagulans
[Main ingredients]Bacillus coagulans, fermentation metabolite.
[Appearance]Light yellow powder.
[Biological feature]
B. coagulans is a Gram-positive rod (0.9 by 3.0 to 5.0 μm in size), catalase positive, spore-forming, motile, and a facultative anaerobe. It may appear Gram-negative when entering the stationary phase of growth. The optimum temperature for growth is 50°C (122°F); range of temperatures tolerated is 30-55°C (86-131°F). Bacillus coagulans is a lactic acid-forming bacterial species within the genus Bacillus.
[Main functions]
1,It can promote the growth of the intestinal bifidobacterium and other probiotics, secrete antibacterial coaguin, inhibit the intestinal harmful bacteria such as proteusbacillus vulgaris, shigella dysenteriae etc., decrease the toxins for example ammonia, amine, indole and so on, eliminate the intestinal paralysis effect that caused by the intestinal tract toxins, therefore avoid the injury to the liver, brain, and derma, enhance the immunity.
2,Improve the feed efficiency, promote the digestion and absorption of the feed nutrients.
3,Regulate the balance of intestinal microflora, improve the activity of pepsin of animals, accelerate intestinal tract movement, alleviate the constipation of female animals, repair the intestinal mucosa, decrease the bowel disease.
4,Enhance immunologic function, improve immunity of the organism and the anti-stress ability of animals
5,Promote the animal growth, shorten the culture-cycle, reduce the feed parameter, increase the weight gain rate and reduce the motality.
6,The product can resist and pass the gastric acid environment in the form of spore, then colonize and grow in the intestinal tract, and proof the cholate.
[Quality index]
Total count of the living bacillus coagulans(billion CFU/g): 30 or 100
Moisture (%): ≤10
Particle size (mesh): 60 - 80
[Scope of application]Livestock and poultry breeding and aquaculture.
[Storage]Keep it in cool, dry and shady place.
[Shelf life]18 months
Our north factory

Our south factory

Our production equipment

Our storage and transportation

Our certifications and honours

Recommended products